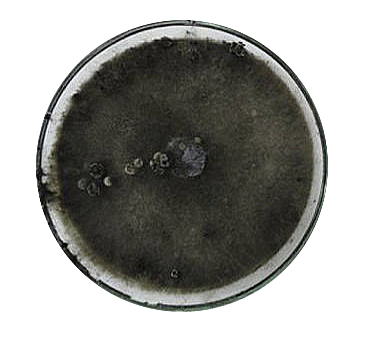

Lasiodiplodia thebromae o muerte regresiva (LSDPPS)
Control de Lasiodiplodia theobromae en el cultivo de Aguacate o Palto.
Lasiodiplodia: Un Patógeno Necrótrofo causante de Muerte Descendente en Cultivos de Aguacate.
Se han incrementado notablemente los cultivos de aguacate debido a la alta demanda actual, hasta un 70% más, convirtiéndose en uno de los cultivos alternativos de gran preferencia en Perú (1).
Uno de los factores limitantes en la producción son las enfermedades que aparecen tanto pre como post cosecha. Por ejemplo, las patologías más representativas en la zona de Piura sobre cultivo de palto son:
Antracnosis
Producida por Colletotrichum gloeosporioides.

Antracnosis en fruto e imagen de microscopía
Pudrición Radicular
Producida por Phytophthora sp.

Muerte por pudrición radicular causada por Phytophthora en plantel de palto.
Marchitez.
Producida por Verticillium spp.

Verticillium en imagen de microscopía y árbol de palto con evidentes signos de marchitez.
1) Fuente (Datos de Rodríguez-Gálvez, datos no publicados)
En los últimos años se ha observado una fuerte incidencia de lesiones o chancros en las ramas de palto con presencia de exudaciones blanquecinas y muerte regresiva que causaron alarma en los agricultores. En Perú, este tipo de sintomatología se creía que están relacionada con Dothiorella spp., ya que también era responsable de chancrosis y muerte regresiva (muerte descendente, desde al ápice hasta la base de la rama) en este cultivo (2).
Un estudio reciente demostró que según las condiciones agro-climáticas, y en concreto en el norte de Perú, la muerte regresiva del palto y la chancrosis se ve principalmente afectada por Lasiodiplodia theobromae (2).
En este blog os presentamos un resumen con la información más relevante para entender el papel de Lasiodiplodia theobromae y su relación con los cultivos de aguacate. Para facilitar su lectura y comprensión dividiremos este blog en tres secciones:
Tabla de contenidos
1. Ficha resumen de Lasiodiplodia theobromae.
Es un hongo patógeno necrótrofo, cuya forma sexuada recibe el nombre de: Botryodiplodia theobromae Pat (1).
Reino: Fungi (hongos).
División: Ascomicota.
Clase: Dothideomycetes.
Orden: Botryosphaeriales.
Familia: Botryosphaeriaceae.
Género: Lasiodiplodia.
Epecie: Lasiodiplodia theobromae.
Distribución geográfica: Dispersión mundial, concentrándose en los trópicos y subtrópicos. L. theobromae se puede establecer en más de 500 especies de hospedadoras, lo cual aumenta su distribución (1).









Cultivos susceptibles al ataque del patógeno Lasiodiplodia theobromae.
Es un patógeno que afecta a una amplia gama de cultivos, los que te mostramos aquí son los más representativos, aunque estudios científicos indican que hay muchos más.
Morfología.
Es un hongo que presenta un desarrollo micelial de color blanco, tornándose posteriormente de color cenizo oscuro hasta volverse negruzco. Las hifas son septadas, formando conidióforos cortos y simples que a posteriori forman conidios (1).

Caracterización morfológica de Lasiodiplodia theobromae. (A) Crecimiento en placa de Petri, (B) Paráfisis (estructuras de protección de gametangios), (C) Conodias maduras e inmmaduras, (D)= Conidias maduras separadas.
2. Ciclo de la enfermedad.
Para entender cómo tratar este tipo de hongos, es fundamental conocer su ciclo vital.
En esta sección os compartimos algunos detalles significativos del ciclo de la enfermedad, en concreto hablaremos del cultivo de cacao, pero los datos son representativos para otros cultivos (1) L. theobromae es un fitopatógeno que sobrevive en el suelo y en restos del cultivo (fuente de inóculo, Figura 1), principalmente en forma de picnidios, esclerocios (4,5) y/o clamidósporas que actúan como estructuras de resistencia en restos de tejidos infectados y/o en el suelo (6).

Ciclo de infección de Lasiodiplodia theobromae en plantas y mazorcas de cacao.
El microorganismo en el suelo podría permanecer como saprófito en las hojas, frutos infectados y fragmentos de ramas caidas y también como clamidosporas. Las esporas contenidas en los picnidios son liberadas al ambiente en condiciones óptimas (mínima 15ºC y optima 28ºC, máxima a 40ºC), siendo diseminadas por el viento, la lluvia (7) o transportadas a través de herramientas e insectos de la familia Miridae (Helopeltis thetvora, H. ammonli y H. theobromae) (8, 9, Figura 1).
Una vez que el hongo llega a la planta, pueden observarse lesiones en frutos (Kranz et al., 1977), brotes y ramillas jóvenes (10), causando graves daños en el rendimiento de mazorcas especialmente en variedades de cacao susceptibles (11, Figura 1).
3. Estudio de la enfermedad en cultivo de palto: Síntomas en campo.
Ahora desarrollaremos la información publicada en el primer reporte científico en Perú en el que se habla del agente causal de la enfermedad, Lasiodiplodia theobromae, y cómo afecta al cultivo de palto (aguacate).
La incidencia de la chancrosis en el estudio fue superior al 80%, lo que demuestra la peligrosidad del patógeno. Los síntomas de muerte descendente se observaron sólo en el 10% de las plantas afectadas (2).

Síntomas de la enfermedad en campo:
Los datos que presentamos en esta sección proceden del estudio realizado en el laboratorio de Fitopatología de la Universidad Nacional de Piura (Perú), donde se obtuvieron aislamientos del hongo a partir de tejido afectado.
Todos provocaron la formación de chancros con secreciones blanquecinas, así como muerte regresiva (2).

(14) Al cortar el fruto afectado se observa la pudrición del mesocarpo que se inicia en la zona de inserción y avanza a todo el fruto.

2: Cancro con exudaciones blanquecinas ubicadas a lo largo de una rama.
3: Cancrosis diseminada en las ramas principales del árbol, obsérvese de las secreciones blanquecinas.
4: Cancro ubicado en la rama aparentemente sana.

6: Cancrosis y exudaciones en el tallo de una planta joven.
7: Cancrosis con exudaciones en tres ramas de una misma planta.
8a: Cancrosis en una rama, las secreciones blanquecinas se retiraron.
8b: Tejido necrotizado ubicado debajo del cancro, luego de realizar un corte longitudinal.
Sintomas de la enfermedad en campo
Más sintomas de la enfermedad en campo.
4. Control Integrado de Lasiodiplodia con T34 Biocontrol®.
1
Uso de variedades resistentes, estar bien informamados de posibles nuevas variedades resistentes a la enfermedad.

2
Abonado: evitar dosis excesivas de abono nitrogenado

3
Poda:
– Vigilar de no hacer heridas para evitar que sea un punto de entrada del patógeno.
– Hacer podas tempranas, aprovechar que la producción de esporas/inóculo será bajo.
– Evitar la poda en momentos de humedad alta (por una elevada liberación de esporas).
– Poda sanitaria, vigilar las ramas con chancros y hacer una poda “generosa” en estas zonas.
– Aspiración de las hojas caídas/infectadas.
– Eliminar los restos de poda de la finca y vigilar no dispersar la contaminación: herramientas de poda, manos, zapatos (movimiento de zonas infectadas a zonas sanas).



5. Glosario.
Necrótrofo: Se dice del organismo que se alimenta de tejidos u organismos muertos. El patógeno produce metabolitos y toxinas que producen la muerte celular, alimentándose de estas células muertas (12).
Picnidio: Son cuerpos fructíferos que poseen una abertura por la que liberan los conidios producidos en su interior (13).
Clamidóspora: Conidio tálico de pared gruesa que actúa como espora de resistencia (14).
Chancros/cancro: Tejido necrótico o muerto, es un síntoma de enfermedad de las plantas causada por hongos patógenos.


6. Bibliografía.
1. Fuente: Moreira-Morrillo, Anthony A., Cedeño-Moreira, Ángel V., Canchignia-Martínez, Fabricio, & Garcés-Fiallos, Felipe R.. (2021). Lasiodiplodia theobromae (Pat.) Griffon & Maul [(sin.) Botryodiplodia theobromae Pat] en el cultivo de cacao: síntomas, ciclo biológico y estrategias de manejo. Scientia Agropecuaria, 12(4), 653-662. Epub 00 de octubre de 2021.https://dx.doi.org/10.17268/sci.agropecu.2021.068
3. https://www.scielo.org.mx/scielo.php?script=sci_arttext&pid=S0185-33092015000100054 Michereff, S. J., Andrade, D.E.G.T. & Menezes, M. (2005). Manejo Integrado de Doenças Radiculares. En Michereff, S. J., Andrade, D.E.G.T. & Menezes, M. (Eds.), Ecologia e Manejo de Patógenos Radiculares em Solos Tropicais, (367-388). [ Links ]
4. Kuswinanti, T., Junaid, M., Surapati, U., & Ratnawaty, R. (2019). A promising microbial use on cocoa: decomposing cocoa waste and controlling Lasiodiplodia theobromae in-vitro. IOP Conference Series: Earth and Environmental Science, 343, 012256.
5. Ogundana, S. K. (1983). Life cycle of Botryodiplodia theobromae, a soft rot pathogen of yam. Journal of Phytopathology, 106(3), 204-213.
6. Vásquez-López, A., Mora-Aguilera, J. A., Cárdenas-Soriano, E., & Téliz-Ortiz, D. (2009). Etiología e histopatología de la muerte descendente de árboles de mamey [Pouteria sapota (Jacq.) H. E. Moore y Stearn] en el estado de Guerrero, México. Agrociencia, 43, 717-728
7. Kranz, J., Schmutterer, H., & Koch, W. (1978). Diseases, Pests, and Weeds in Tropical Crops. Soil Science, 125(4), 272.
8. Ploetz, R. C. (2003). Diseases of Tropical Fruit Crops. CABI Publishing. Wallingford, UK. pp 76-77.
9. Martoredjo, T., Ardy, D., Hermansyah, H., & Sunardi, T. (1995). Peran infeksi jamur dalam memperparah kerusakan buah kakao akibat serangan Helopeltis sp.Jurnal Perlindungan Tanaman Indonesia, 1(1), 28-32.
10. Adu-Acheampong, R., Archer, S., & Leather, S. (2012). Resistance to dieback disease caused by Fusarium and Lasiodiplodia species in cacao (Theobroma cacao L.) Genotypes. Experimental agriculture,48(1), 85-98.
11. https://dicciomed.usal.es/palabra/necrotrofo-fa#:~:text=adj.,de%20tejidos%20u%20organismos%20muertos.
Se trata de hongos necrotróficos que afectan a una amplia variedad de cultivos entre los que se incluyen la lechuga, el repollo, tabaco, girasol, patata, alfalfa, zanahoria, apio, pepino, berenjena, leguminosas, tomates y melones, entre otros.
Dentro de las especies del género Sclerotinia encontramos a los agentes causales de algunas enfermedades vegetales como por ejemplo el Moho blanco, el llamado damping-off (marchitamiento fúngico) o la enfermedad conocida como “Dollar Spot” (Sclerotinia homeocarpa).
También se ha de aclarar que el marchitamiento fúngico no solo lo provoca este hongo, sino que especies del género Phytophthora, Rhizoctonia, Botrytis y Pythium, también están relacionados con esta enfermedad.
¿SabÍas Qué...?
…Los hongos necrotroficos son aquellos que segregan compuestos que matan a las células vegetales para posteriormente absorber sus nutrientes.



